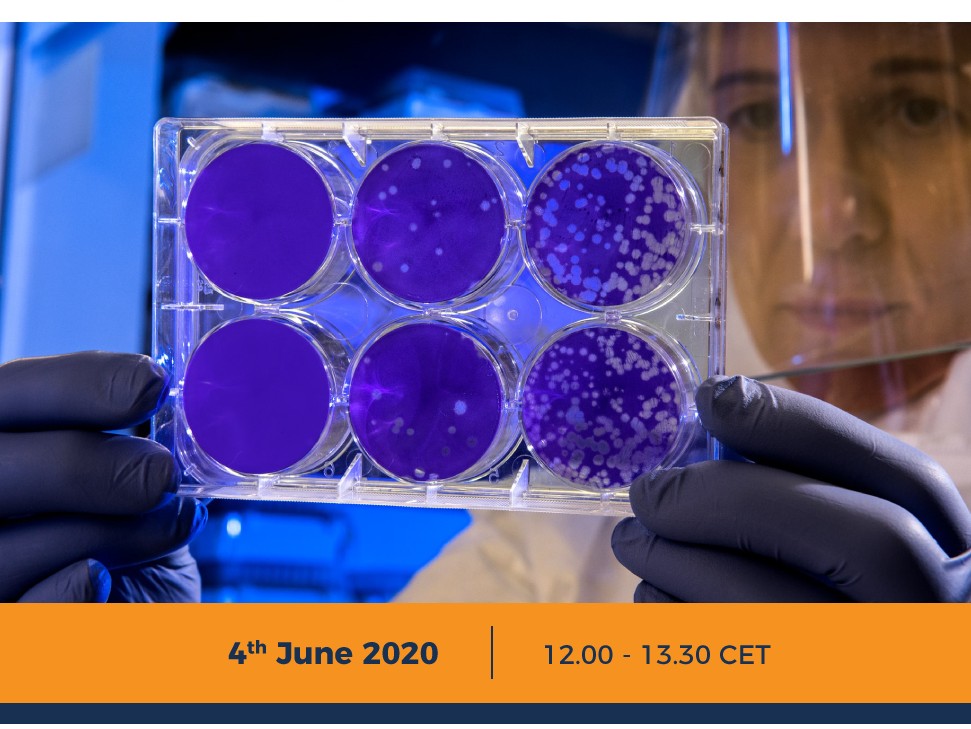

DIGI-B-CUBE Webinar - New solutions for Clinical Research, Diagnostics and Treatment
The organisers will support participants in searching for partners to apply for DIGI-B-CUBE calls for proposals.
Link for registration: https://platform.digibcube.eu/eventApplication(opens in new window)
More information: https://digibcube.eu/2020/05/28/new-solutions-for-clinical-research-diagnostics-and-treatment/(opens in new window)